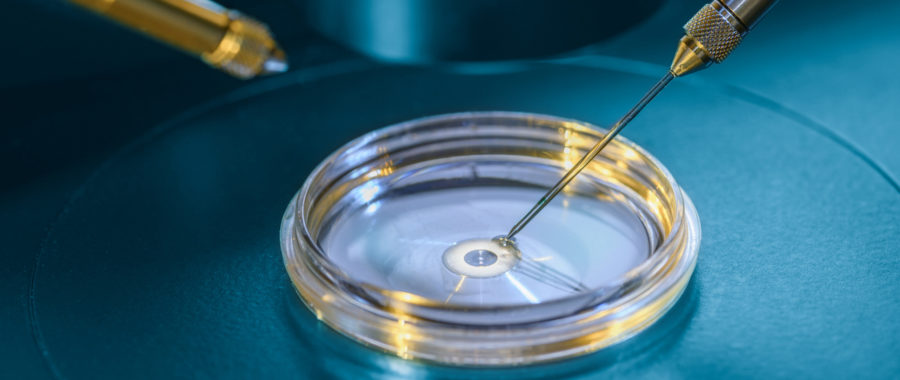
intracytoplasmic-sperm-injection

Kiran Infertility center is providing one of the best ICSI treatment in Bangalore. We are also providing world class treatment options like IVF, Test Tube Baby, Oocyte Donation, Embryo Donation, Oocyte/Embryo Freezing.
ICSI or Intracytoplasmic sperm injection
Intracytoplasmic sperm injection is a micromanipulation technique used in the process of in vitro fertilization (IVF). It involves injecting a single sperm into the cytoplasm of an egg under a microscope (i.e. injecting the sperm through the egg’s shell so that the sperm does not need to penetrate the shell in order to fertilize the egg).
In ICSI, all the steps are similar to the procedure of IVF, except the step of fertilization. Normally in IVF, one egg is mixed with 200,000 sperms and one of the sperms fertilizes the egg on its own. In contrast, in ICSI, each egg is held and injected with a single live sperm. This micro-fertilization is done with the help of a machine called the Micromanipulator.
Until the 90’s, males with very low counts (less than 5 million per ml) or poor quality sperms had no hope of fathering their own genetic children. This problem was surmounted by the new breakthrough of ICSI, which took place in Brussels and Belgium in 1992.
Since then, many such patients have fathered a child. We started our own ICSI program in 1998-99 and have performed more than 10,000 cycles till date with a success rate of 40 to 50% per cycle, which is comparable to the best units in the world.
Steps Involved in ICSI Procedure
- Controlled ovarian stimulation with drugs (GnRH) Analogues and Gonadotrophins to produce many eggs.
- Monitoring of follicles and egg development with the aid of Vaginal Sonography and serial Estradiol hormone estimation.
- Administration of HCG injection, (Human Chorionic Gonadotrophins) when at least two leading follicles are 18 mm in diameter.
- Oocyte or egg retrieval under short general anesthesia, 35 to 36 hours after HCG injection.
- Identification and isolation of eggs in the laboratory.
- Sperm collection and processing in the lab. In the case of Azoospermia (no sperms in the semen) the sperms are collected directly from the testes with the procedures of PESA/MESA/TESE or TESA.
- Stripping of the cumulus of the eggs in the laboratory with the help of an enzyme called “hyaluronidase”. Placement of eggs into small droplets of culture media under oil.
- Placement of sperms into small droplets of PVP under oil. Immobilization of the sperm with a microinjection needle (Diameter of 7 microns) and aspiration of the immobile sperm into the needle after crushing the tail portion of the sperm).
- Holding the egg with a holding pipette and injection of the immobilized sperm into the held egg. Placement of these eggs into the incubator for 2 to 5 days.
- Embryo formation 2 to 5 days after fertilization.
- Embryo transfer of good quality embryos back to the womb, after 2 (four cell embryo), 3 (six-eight cell embryo) or 5 (Blastocyst stage) days after egg removal.
Who would need ICSI ?
- Males with severe sperm factors such as low count (less than 5 million), very poor motility or a high degree of abnormal sperms. Males with Azoospermia, where there is no sperm present in the semen. The Azoospermia may be of the obstructive type where there is a production of sperms in the testis but blockage of the conduction system, which brings the sperm out into the semen. Alternately, the Azoospermia may be of the non-obstructive type, where there is a failure of the testes to produce sperms. Nowadays, in both these types of Azoospermia, sperms can be isolated directly from the testis by Testicular Biopsy.
- Retrieval Techniques of PESA/TESA/TESE and subsequently, ICSI can be performed on the following cases: Males with sperm antibodies.
- Males with Ejaculated Dysfunction due to spinal cord injury or malfunction such as Quadriplegics or Paraplegics.
- Patients with Retrograde Ejaculation (ejaculation of the sperm into the urinary bladder) who fail to become pregnant with IUI.
- Patients where fertilization has failed with In-Vitro Fertilization.
Special Cases
In our Clinic, we also believe in doing ICSI on patients who have had a previous history of Tuberculosis or Endometriosis, as we believe it gives better fertilization rates than standard IVF (this is a personal experience not supported by international literature).
Success Rate
Our Cumulative success rates for ICSI are in the region of 80 to 90% in both Azoospermia and Non-Azoospermia patients.
